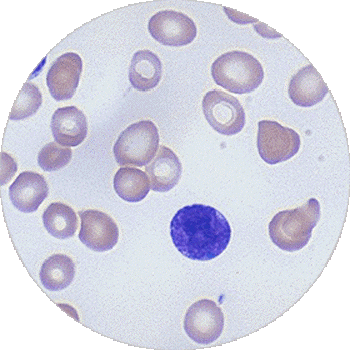

为您节约时间,可输入您的号码点击回电,直接电话咨询!
很多人都暗自庆幸自己没有白血病,可能大家也都有这种感觉,近年来白血病患者越来也多,这里边的原因跟我们生存的环境不是不无关系。因此大家需要多了解一些白血病的知识,做到早预防早治疗。尤其是老年人更应该加强这些疾病方面的知识。下面就由广州中医药大学金沙洲医院国际肿瘤诊疗中心的胡群峰 教授主要就白血病的早中晚期症状和具体表现形式做一些分析:
白血病早期症状有以下几点:
1、贫血: 常常为白血病的首发症状,主要表现为脸色苍白,自觉虚弱乏力、多汗,不论在活动或是在休息时,都觉得气促、心跳加快。随着时间的推移逐渐加重。贫血越重往往提示白血病越严重。
2、发热 :半数以上的患者以发热为早期表现,可为38度以下的低热或39度甚至40度以上的高热。
3、原因不明无痛肿大 :大部分白血病患者有浅表淋巴结的肿大,以颌下、颈部、锁骨上、腋下及腹股沟处多见,往往没有明显疼痛,体检可发现肝脾肿大,胸骨下有明显的压痛,这是大量白血病细胞浸润骨髓的表现。
4、出血 :白血病以出血为早期表现者近40%。出血可发生在全身各个部位,常见于皮肤不明原因的瘀斑、口腔、鼻腔、牙龈出血、月经过多等。
5、头痛、恶心、呕吐、偏瘫、意识丧失等神经系统症状是白血病对脑细胞和脑膜浸润的缘故。
白血病癌细胞变化展示图
白血病中晚期症状有以下几点:
1、心脏:大多数的晚期白血病患者都会表现为心肌白血病浸润,出血及心外膜出血,心包积液等不良反应。
2、肾脏:医学数据统计,有百分之四十以上的晚期白血病患者都会出现肾脏病变。
3、骨与关节:管关节疼痛是白血病的常见症状,在早期白血病,患者也会有骨关节疼痛,但是随着病情的加重骨关节疼痛越来越明显。
4、口腔:患者的齿龈肿胀、出血、白血病浸润多见于晚期白血病,严重者整个齿龈可极度增生,给患者带来巨大的疼痛。
5、胃肠系统:由于白血病细胞在体内的的不断扩散,使得患者的胃肠受到侵润,因此患者经常会表现为恶心呕吐、腹胀等不良现象。
专家提醒广大白血病患者,白血病早期发现有利于早期治疗,一旦有以上的症状出现的时候,应该积极地到医院进行检查、治疗,不能任其发展,只有积极地治疗这样的疾病,才能远离疾病的危害。
早期诊断、早期治疗是治疗白血病的黄金法则
确诊疾病的时候,无论病情进展到哪个时期,都不要放弃治疗,及时选择恰当疗法进行治疗,抑制病情进展还是不成问题的。
白血病该怎么治疗,选择什么治疗方式?
手术、放化疗都是治疗白血病的常规治疗方法,对于早期肿瘤治疗还是有很大的治疗效果。但是手术、放化疗无法清除多余的肿瘤细胞,对术后的复发和转移也无能为力。但是传统的治疗方式易扩散副作用大,许多的肿瘤患者死于手术、放化疗后的细胞转移扩散和副作用。那么该怎么办呢?广州中医药大学金沙洲医院国际肿瘤诊疗中心的WB-1无创全身热疗系统的出现,让肿瘤患者重新看到了生命的希望。WB-1无创全身热疗系统治疗白血病效果更明显更突出,有效减少复发。
为什么选择WB-1无创全身热疗系统,它有什么优势?
由于肿瘤组织在高温作用下散热困难,热量易聚集,形成巨大的储热库,当温度达到39.5℃—41.5℃持续60~120分钟,就能杀灭肿瘤细胞。而正常细胞可以长时间耐受39.5℃~41.5℃高热,从而“热”死癌细胞而正常细胞不受影响。此外,WB-1无创全身热疗系统还能激活处于麻痹状态的免疫系统,产生抗肿瘤免疫,从而抑制和杀灭转移灶或亚临床病灶。
温馨提示:对于白血病一定要早发现早治疗,并选择正确的治疗方式,以免加重病情导致疾病恶化,目前大多数患者选择广州中医药大学金沙洲医院国际肿瘤诊疗中心的“WB-1无创全身热疗系统”治疗,在肿瘤治疗领域,权威指出:WB-1无创全身热疗系统成为最令人瞩目、最鼓舞人心的焦点,可有望达到完全消灭癌细胞并根治的目的,是二十一世纪肿瘤综合治疗模式中最活跃、最有发展前途的一种治疗手段。近期患者较多,专家号紧张,您可提前在线预约专家,避免了“一号难求”的现象,到院可直接就诊。广州中医药大学金沙洲医院国际肿瘤诊疗中心将便捷、高效的服务于您的就诊全程。您也可拨打全国免费健康热线:020-81116661 或020-81116661进行详细咨询
点击快速进入预约挂号系统
Nelo351
我今年6月份乳腺癌复发,我的一个癌症朋友介绍我来广州中医药大学金沙洲医院做全身热疗,他也是前段时间在这边做热疗跟粒子植入。我做了5个疗程的热疗后,复查发现病情得到了控制,在做热疗的时候人也没其他不适。
健康平安251
我妈妈一段时间身体各种不舒服,到医院检查发现是肺癌,打听到邓医生治癌症很厉害,15年6月份就到金沙洲医院住院,做了热疗和化疗,幸好也没有出现别人说的化疗副作用,觉得很奇怪的问了邓医生,说是因为用了小剂量的化疗,这才没有出现化疗的副作用。
淡然153
天有不测风云,我在12年单位体检胆管癌,在当地医院手术后无接受其他治疗,但在两年后复查后发现转移,马上转至广州中医药大学金沙洲医院接受更好的治疗,做了4次全身热疗和小剂量的化疗,现在只要定期复查就好了。
发布成功!评论待院方审核后才能生效!

(本网站已加密,绝对保障个人隐私)